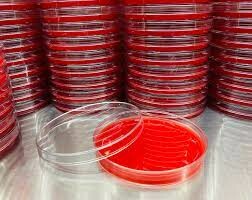
MDL ASIA 1

Đăng nhập để tiếp tục
Bằng việc đăng nhập, bạn đồng ý với Nội quy mạng xã hội, Điều khoản dịch vụ và Chính sách quyền riêng tư của Note8.vn liên quan đến thông tin riêng tư của bạn.
Tìm kiếm công việc
Ứng dụng của tôi
👤 Hồ sơ Nhà tuyển dụng
Quản lý thông tin và hình ảnh thương hiệu công ty
⭐ Đánh giá Công ty
Theo dõi & phản hồi review từ ứng viên
📊 Phân tích
Xem dữ liệu, insight về ứng viên & thị trường
💼 Tuyển dụng
Đăng tin, quản lý job và ứng viên
📢 Quảng cáo
Tăng hiển thị thương hiệu & tin tuyển dụng
Khám phá thêm dành cho doanh nghiệp
🏢 Tạo trang công ty nổi bật
Tăng nhận diện thương hiệu, thu hút ứng viên chất lượng
✏️ Cập nhật thông tin công ty
Luôn giữ profile chuyên nghiệp và đáng tin cậy
📌 Đăng tin tuyển dụng ưu tiên
HOT
Hiển thị nổi bật, tiếp cận nhiều ứng viên hơn
💬 Phản hồi Review & phỏng vấn
Xây dựng uy tín và tương tác với ứng viên
📍 Ghim Review nổi bật
HOT
Đưa các đánh giá tốt lên vị trí nổi bật
⚖️ So sánh với đối thủ cạnh tranh
New
Phân tích vị thế công ty so với thị trường
📣 Quảng cáo trên trang đối thủ
New
Tiếp cận ứng viên ngay tại trang công ty khác
📈 Xu hướng đánh giá & Phỏng vấn
Nắm bắt insight thị trường theo thời gian
📊 Review Analytics
Báo cáo chuyên sâu về hành vi & đánh giá ứng viên
Đăng ký Premium
Nâng cấp ngay
Chỉ từ 300.000đ / tháng
Reviews
- Reviews
- Việc làm
- Mức lương
- Phỏng vấn
- Tổng quan

Nhà tuyển dụng?
Đăng ký Tài khoản Miễn phí
MDL ASIA
Bán hàng/ Kinh doanh
🔥 Có 25 lượt xem trong tháng qua
Dành cho doanh nghiệp
Bạn muốn giới thiệu không gian làm việc và văn hóa công ty mình qua ảnh?
Tuyển dụng mới nhất tại MDL ASIA
Kỹ Thuật Viên Thí Nghiệm Phòng Lab/Lab Technician -
MDL ASIA Đăng 30+ ngày trước Hết hạnKỹ Thuật Viên Thí Nghiệm Phòng Lab/Lab Technician
MDL ASIA Đăng 30+ ngày trước Hết hạnNhân Viên Kế Toán Nội Bộ
MDL ASIA Đăng 30+ ngày trước Hết hạnKỹ Thuật Viên Thí Nghiệm Phòng Lab/ Lab Technician
MDL ASIA Hồ Chí Minh, Vĩnh Long Đăng 30+ ngày trước Hết hạnNhân Viên Đóng Gói, Giao Nhận
MDL ASIA Đăng 30+ ngày trước Hết hạnNhân Viên Kế Toán Kho
MDL ASIA Đăng 30+ ngày trước Hết hạnNhân Viên Kinh Doanh - Lĩnh Vực Hoá Chất Và Vật Tư Xét Nghiệm
MDL ASIA Đăng 30+ ngày trước Hết hạnNhân Viên Kinh Doanh Thiết Bị Y Tế
MDL ASIA Đăng 30+ ngày trước Hết hạnNhân Viên Giao Nhận
MDL ASIA Hồ Chí Minh Đăng 30+ ngày trước Hết hạnNhân Viên Đóng Gói - giao nhận
MDL ASIA Hồ Chí Minh Đăng 30+ ngày trước Hết hạn
Xem thêm tất cả
Bạn làm việc tại MDL ASIA? Chia sẻ kinh nghiệm của bạn

MDL ASIA
Click để đánh giá
Tăng cường sự hiện diện của công ty bạn bằng cách quản lý hồ sơ công ty của bạn.
Thông tin liên hệ
Trụ sở công ty
Địa chỉ: L17-11, Tầng 17, Tòa nhà Vincom Center, 72 Lê Thánh Tôn, Phường Bến Nghé, Quận 1, Thành phố Hồ Chí Minh, Việt Nam
Xem bản đồ
Cập nhật Facebook gần đây
Top Công Ty
So sánh hiệu quả hoạt động của công ty bạn với các đối thủ cạnh tranh